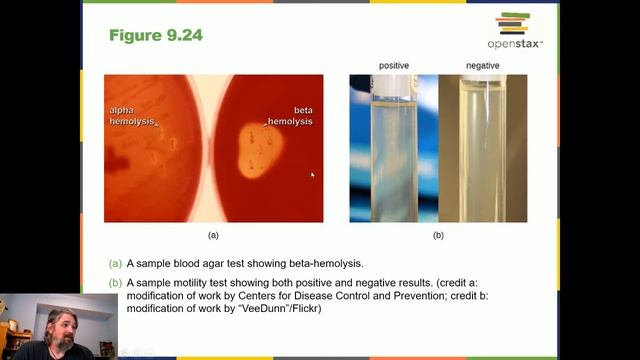
Lecture 2/18 смотреть онлайн

Автор / Канал: Chemistry Adventures Страница 10

Марат Ақару "Тәуелсіз ел ұраны"әні

AoT ⌞The Rumbling⌝ The Final Season Part 2 Opening | Bass Boosted

Дебют ДонНТУ 2015. ФМФ. Танец

Science b**ch

Neon (dubstep) - Tristam, Doctor P, Jenna G FULL HQ 1080p

How Much Taller? - Amanda Seyfried vs Selena Gomez!

Просмотор ролика с смешон

Tedx НИШ ХБН г.Шымкент

837 W Wolfram 310-$1020

Clinical Chemistry: Calcium, Phosphate and Anion Gap

Индийский клип из фильма Наступит Завтра или Нет

Fluimucil 600 mg Tablet

Первый снег в Эссо
Lecture 2/18

New 2024 Canyon Neuron, now with Bosch SX motor - Lighter is better right?

индийская фотосессия

Переваги сферичної гранули органічного добрива на основі курячого компосту. Аргументи від виробника

Episode 2 Farzi: The Fake News Quiz

серый и лёд

ECG 2090 Pro Conductivity EC Salinity Resistivity Meter Controller Analyzer BOQU Instrument

11 SMA Pekan 12 Kesetimbangan Kelarutan 2

Алёна Апина. 2 декабря 2014 года. Прямая трансляция на Радио Шансон.

NaCO3+NH3.H2O+HCl

Прощание 👍👍👌👌👌❤
За каждым успешным каналом стоит личность, идея и сотни часов кропотливого труда. Если вы здесь, значит, автор «Chemistry Adventures» уже сумел зацепить ваше внимание своим уникальным стилем или подачей. А мы на RUVIDEO позаботились о том, чтобы вы могли изучить весь архив его работ в максимально комфортных условиях — без лишней суеты и преград.
Почему за работами канала «Chemistry Adventures» так интересно наблюдать? Всё просто: это честный контент, который находит отклик в сердцах зрителей. На нашем ресурсе вы можете смотреть онлайн все видео любимого автора бесплатно и в хорошем качестве. Нам важно, чтобы вы видели каждую деталь и слышали каждый нюанс, поэтому мы используем только стабильные плееры из открытых источников Rutube.
Следите за новинками канала, пересматривайте старые шедевры и открывайте для себя новые грани творчества «Chemistry Adventures». Мы постоянно обновляем ленту, чтобы у вас под рукой всегда были самые свежие выпуски. Никаких сложных регистраций — только вы и творчество, которое вдохновляет. Приятного вам путешествия по миру авторского контента на RUVIDEO!
Видео взято из открытых источников Rutube. Если вы правообладатель, обратитесь к первоисточнику.